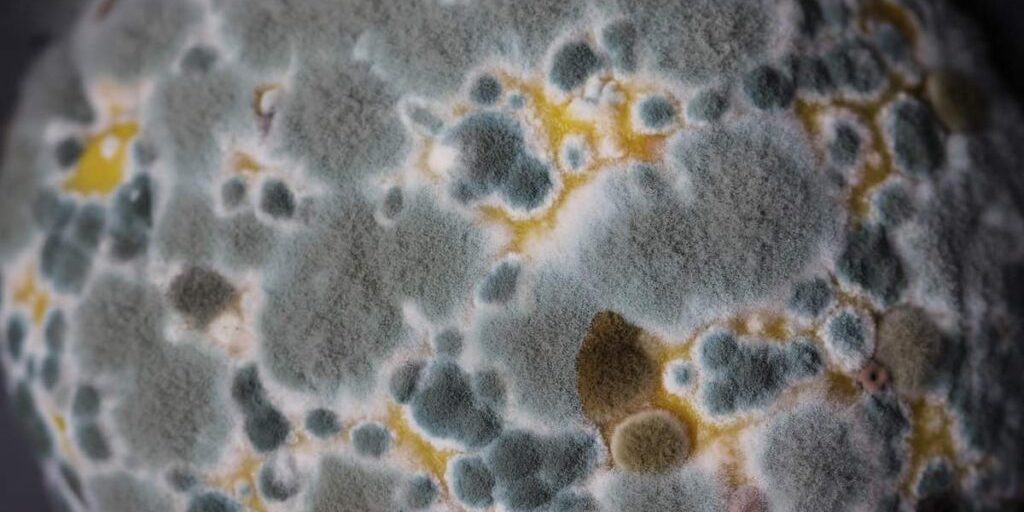
mold-remediation-1024×683 Mold remediation image

You may be wondering what causes black mold. The dark color of this substance makes it noticeable. It usually forms in basements and other damp places. If you have water damage or a malfunctioning HVAC system, you should check for signs of mold.
What is Black Mold?
When people refer to black mold, they usually mean the toxic variety of mold called Stachybotrys chartarum. There are other kinds of mold, black-colored, that are not as dangerous as the less-common, toxic kind. Even the non-toxic molds can cause health problems, however, especially in individuals who are allergic to mold.
What Causes Black Mold to Grow?
There are many causes of black mold, but the most common are water damage and moisture. Black mold thrives in moist environments, so if you have a leaky roof or plumbing, or your home is in a humid climate, you are at risk for black mold. Other causes of black mold include inadequate ventilation, dirty HVAC systems, and flooding.
Is Black Mold Dangerous?
Black mold is a potentially dangerous substance. It can be harmful if exposed for long periods of time. This type of fungus can cause many types of illnesses, from headaches to sneezing. If you notice any of these symptoms, you should visit a doctor immediately. If you notice any of these symptoms, contact a mold remediation specialist. He or she can assess whether you have been exposed to this fungus.
What Are Other Symptoms of Black Mold?
In addition to symptoms such as itchy eyes, sneezing, and wheezing, people with severe black mold exposure may suffer from asthma and chronic lung disease. The fungus can also cause skin rashes and redness around the eyes. More serious symptoms include memory loss, dizziness, fatigue, and infertility.
How Do I Know if I Have Black Mold?
These are the most common indicators of black mold growth:
- The presence of black, green, brown, or white mold
- Respiratory problems, skin irritation, and headaches
- A musty odor
- Water damage
In case you notice a spot that you suspect might be black mold, call a licensed professional to examine the area. They will identify the source of the mold and treat it for you.
How is Black Mold Treated?
There are many ways to treat black mold. Taking preventative measures is crucial to minimizing your exposure to it and limiting the number of places it can grow.
How to Get Rid of Black Mold
If you have black mold in your home, it is important to get rid of it as soon as possible. There are several things that you can do to get rid of black mold:
- Remove the moldy material
- Clean the area with a detergent and water
- Apply a disinfectant to the area
Since mold thrives in moist, humid environments, it’s important to minimize these types of environments in your home. Ventilate these areas and keep them as dry as possible to avoid further infestations.
Black mold is a scary threat for homeowners and can cause a lot of stress and worry. By having a service like Certified Mold Removal test and treat any possible mold in your home or office, you can rest assured that any possible negative health problems are mitigated by an experienced professional. Get in touch with us today.
Sources